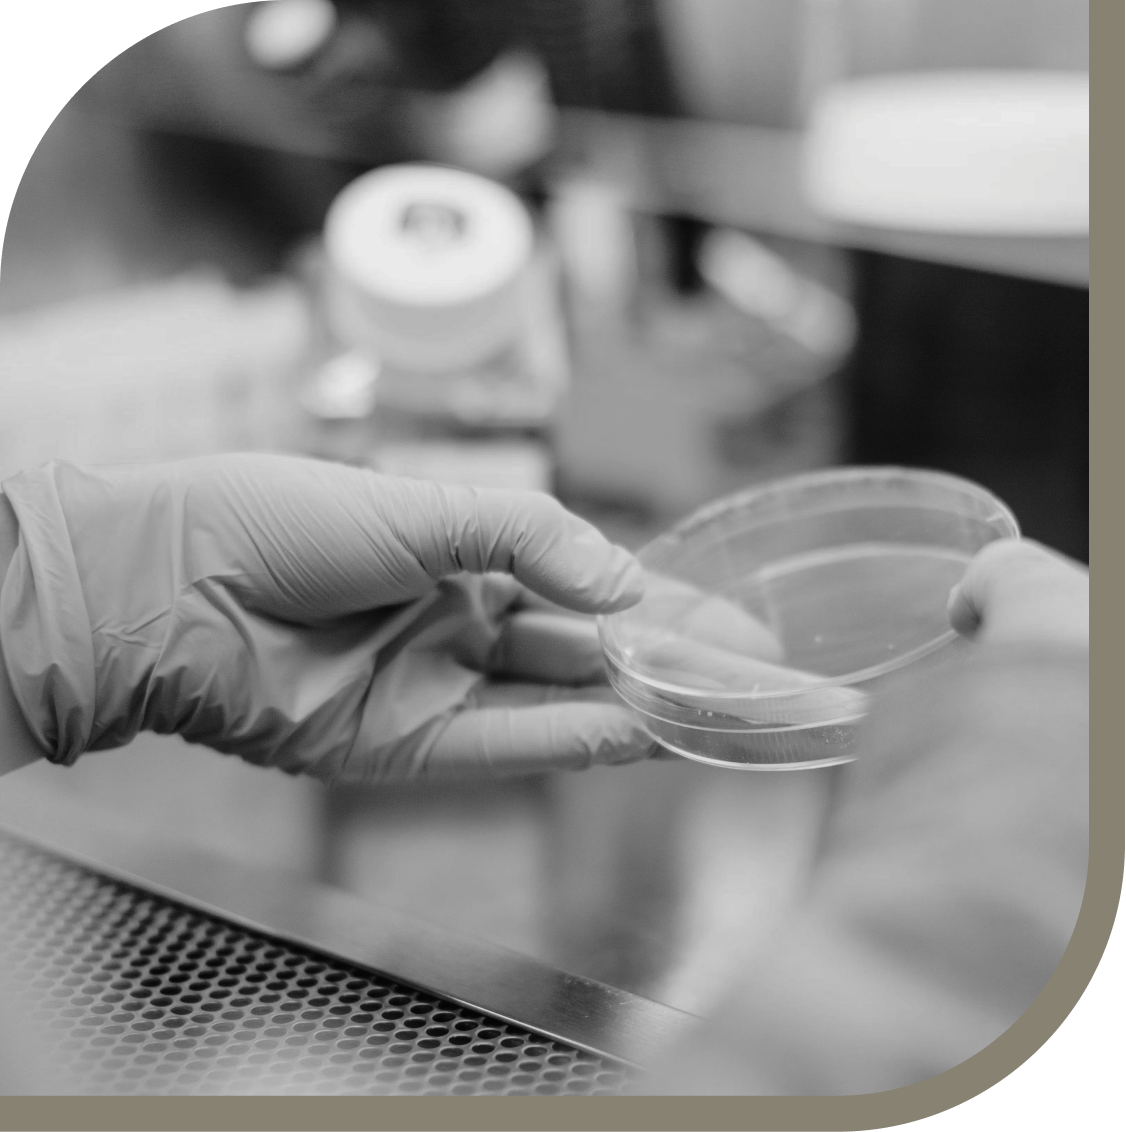

PRODUCT DESIGN
People are always at the core of our design process; we prioritize their needs and experiences. We never create in a vacuum without involving users, ensuring their valuable input and feedback guide our designs.
We create visually appealing and intuitive software that transforms everyday tasks into seamless, enjoyable experiences for a more efficient digital life.
Embracing inclusivity, our designs adhere to WCAG guidelines, ensuring a seamless and enjoyable experience for users of all abilities.
DEVELOPMENT
Steadfast security measures, using Snyk, provide a solid foundation to safeguard your sensitive data and maintain compliance.
Our robust API's are designed to grow with your healthcare organization, ensuring seamless performance as your needs evolve.
We create visually appealing interfaces that prioritize user experience, resulting in effective front-end experiences that streamline interactions and enhance overall functionality.


DATA SCIENCE
We unify data from various sources, optimizing workflows and decision-making through a robust data architecture. Utilizing FHIR and HL7 standards, we enable seamless access and interoperability for efficient data management
Our data experts transform raw information into powerful insights, empowering you to craft data-driven strategies for success.
We deliver HIPAA-compliant, bespoke data solutions that cater to your organization's needs, fueling informed decisions and enhanced patient care.
frameworks
As experts in the Luma Framework, we proficiently guide the innovation process, identifying challenges and formulating effective, impactful solutions.
By discovering and focusing on key problems and needs, we catalyze your project with methodologies that streamline execution and produce rapid results.
Clients are essential players in all of the work that we do, shaping outcomes through active participation and valuable insights.


Hey there, this is the default text for a new paragraph. Feel free to edit this paragraph by clicking on the yellow edit icon. After you are done just click on the yellow checkmark button on the top right. Have Fun!
Hey there, this is the default text for a new paragraph. Feel free to edit this paragraph by clicking on the yellow edit icon. After you are done just click on the yellow checkmark button on the top right. Have Fun!
FEATURED PROJECT
We created a mobile app for a clinical trial for dementia caregivers. Our approach was collaborative, from design to implementation, resulting in an innovative platform.
We conducted extensive research to understand the unique needs of caregivers and patients, developing assessment tools, resources, and communication features. The app offers a user-friendly interface with high standards of privacy and security.
Caregivers can provide more effective care, seek guidance, and manage their own well-being. This leads to an improved quality of life for both patients and caregivers.
Our team developed a healthcare data portal to empower pharmaceutical sales reps to more accurately understand their regions customers and physicians needs.
We made healthcare data more available and actionable. By shortening the process from collection to analysis, we helped this regional hospital association speed up the delivery of critical insights.
DeveloperTown was able to develop a multi-app solution allowing users to receive a personalized experience which could be updated and iterated upon quickly.
There’s no such thing as a ‘one-size-fits-all’ engagement.
DeveloperTown comes alongside you in the capacity that’s right for you.

Option 1
Let us manage and deliver your software products from start to finish, providing expert guidance and support every step of the way.

Option 2
Our hybrid team approach combines the strengths of your product team with our expertise and support.

Option 3
Scale your team, enhance productivity, and expedite success by seamlessly integrating skilled professionals into your existing workforce.
We help organizations realize their technology potential. With an experienced and skilled team, we partner with companies of all sizes to take their technology visions from concept to reality.

Our product definition process is built upon thorough market analysis, code audits, and UX/UI assessments. Our comprehensive approach allows us to evaluate your organization's needs and the current market landscape, providing valuable insights into the most effective course of action.
Based on our findings, we may recommend building a new product, enhancing an existing product, or refraining from development altogether. This strategic guidance helps ensure that your organization invests its resources wisely, optimizing outcomes and maximizing the potential for success.
Collaboration is key to successful product discovery, and the LUMA framework makes it easy for businesses to involve different consulting disciplines in the process. From UX designers to business analysts and technical experts, each team member can bring their unique perspective to the table.
By working together, businesses can ensure that their product ideas are well-informed and well-vetted, reducing the risk of costly mistakes down the line. With the LUMA framework as a guide, we leverage the strengths of each team member to identify your project needs and a path forward.

Our Engagement Managers, Designers, and Developers form a cohesive, interdisciplinary team committed to delivering impactful products that delight users. Our design team conducts user research, ensuring a thorough understanding of user needs and preferences. After researching we design wireframes, conduct user testing, and create hi-fidelity visuals.
Our development team works with Engagement Managers to build out API’s and the frontend and bring designs to life. We’ll QA everything for you before engaging in user acceptance testing and delivering the final product.

“We are not going to wait for the future of healthcare to make it to us. We’re going to build it.
And we’d like to build it with you.”
- Luke Pittman, MD
VP OF HEALTHCARE SOLUTIONS
Strategy
Design
Comprehensive UX Audit
UX Research
UX Design
Interface Design
DesignOps
Website Design
Execution
Web App Development
Mobile App Development
AI / Machine Learning
© 2022 DeveloperTown • 855-338-8696 • 5255 Winthrop Avenue, Indianapolis, IN 46220